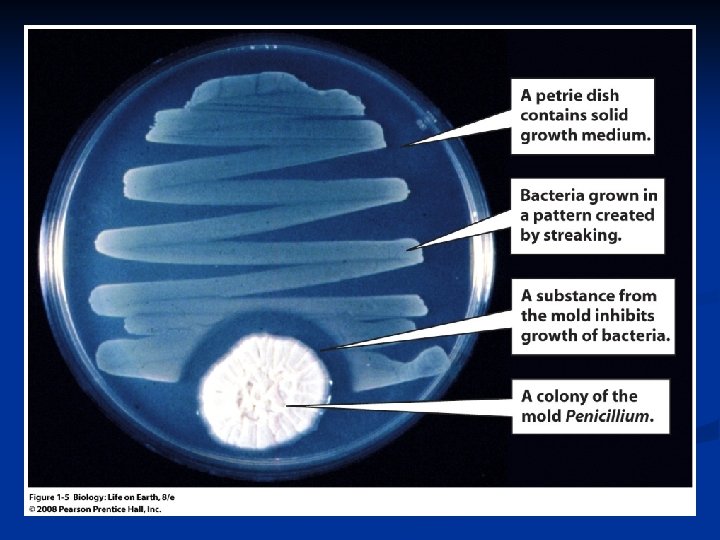

Scientific Method El Mtodo Cientfico Estudio del Captulo

- Slides: 22
Scientific Method El Método Científico Estudio del Capítulo 1 Págs. 1 -18
Pasos
Hipótesis y Teorías n Hipótesis verificadas repetidamente e indefinidamente
Teoría refutada n Teoría de la generación Espontánea De materia orgánica pueden surgir espontáneamente organismos n Surge controversia entre Defensores y Opositores n Ver experimento de las moscas de F. Redi n
Application to Everyday Problems n Assume you are late for an appointment and hurriedly try to start your car 1. Observation: The car won’t start
Descubrimiento de la Penicilina n 1929: Alexander Fleming Cultivaba bacterias n Contaminación con el hongo Penicillium notatum n Aplicó el método científico: Observación, hipótesis n Descubrimiento de sustancia inhibitoria de crecimiento de bacterias. n
Science Is a Human Endeavor 1. 2. 3. In the 1920 s, bacteriologist Alexander Fleming grew bacteria in cultures One of the bacterial cultures became contaminated with a mold Fleming nearly destroyed the culture when he noticed the mold (Penicillium) inhibited bacterial growth in the culture
Teorías Hipótesis verificadas repetidamente. n Se pueden descartar con el paso del tiempo a la luz del nuevo conocimiento. n n Ej. La abiogénesis
Science is a Human Endeavor 4. 5. Fleming hypothesized that the mold produced an antibacterial substance Further tests using broth from pure Penicillium cultures lead to the discovery of the first antibiotic, penicillin
Science Is Based on Reasoning n Inductive Reasoning Used in the development of scientific theories n A generalization is created from many observations n e. g. , the cell theory (all living things are made of one or more cells) arises from many observations that all indicate a cellular basis for life n
The Scientific Method Scientific experimentation tests the assertion that a single variable causes a particular observation n The experiment must rule out the influence of other possible variables on the recorded observations n
The Scientific Method Controls are incorporated into experiments n Controls keep untested variables constant n Scientific method is illustrated by Francesco Redi’s experiment n